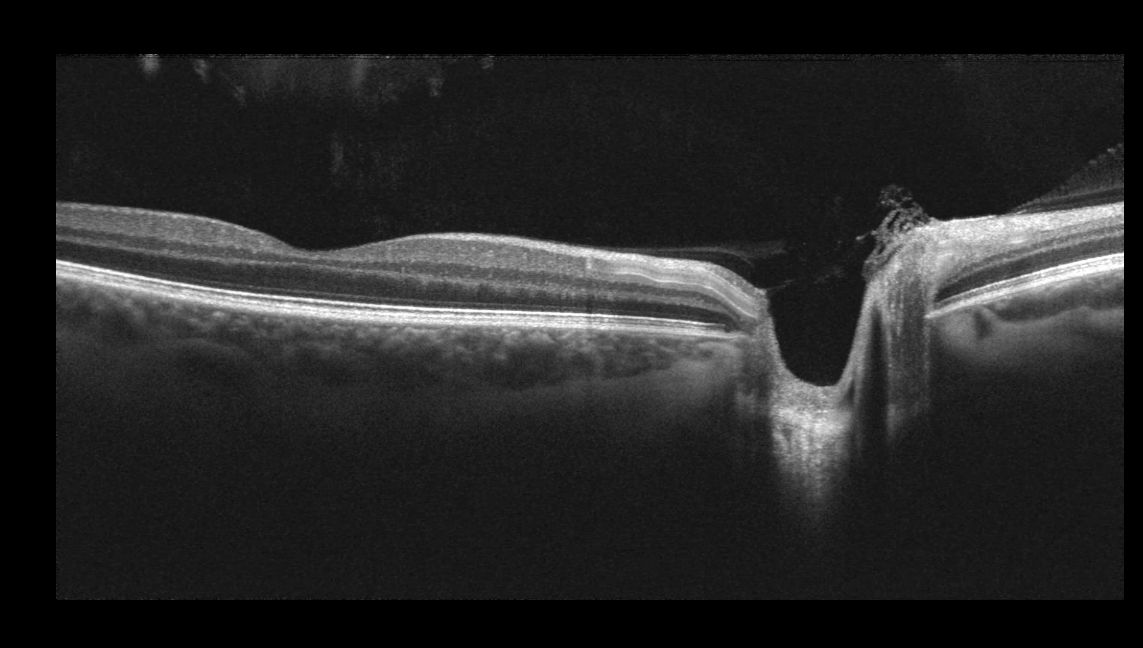

Advanced Eye Testing Technology
Clear vision starts with clear understanding. Technology plays an important role in eye care, but it is how it supports careful clinical judgement that truly matters.
At On Point Eyecare, we use diagnostic imaging to help us see subtle changes early, explain findings clearly, and make informed decisions about your eye health. This allows for thorough assessments and meaningful conversations, not rushed appointments.
Our technology is used thoughtfully and only when clinically appropriate, helping us protect your long-term eye health while giving you clarity and confidence in your care
Technology That Supports Better Eye Care

Optos Ultra Widefield Retinal Imaging
Optos retinal imaging allows us to capture a wide-angle view of the retina in a single image, including areas that aren’t always visible during a standard eye examination.
This broader view supports earlier detection and ongoing monitoring of retinal and diabetic-related changes, helping us build a more complete understanding of your eye health.
For you, this means clearer explanations, greater reassurance, and confidence that we’re seeing the full picture, not just what’s immediately visible.
Optos Ultra Widefield Retinal Imaging

Optos retinal imaging allows us to capture a wide-angle view of the retina in a single image, including areas that aren’t always visible during a standard eye examination.
This broader view supports earlier detection and ongoing monitoring of retinal and diabetic-related changes, helping us build a more complete understanding of your eye health.
For you, this means clearer explanations, greater reassurance, and confidence that we’re seeing the full picture, not just what’s immediately visible.
Optical Coherence Tomography (OCT)
OCT provides detailed cross-sectional images of the retina and optic nerve, allowing us to assess the eye’s deeper structures with precision.
It plays an important role in identifying and monitoring conditions such as glaucoma and macular disease, often before noticeable symptoms develop.
Used thoughtfully and when clinically appropriate, OCT helps guide informed decisions and long-term eye health planning.

Optical Coherence Tomography (OCT)
OCT provides detailed cross-sectional images of the retina and optic nerve, allowing us to assess the eye’s deeper structures with precision.
It plays an important role in identifying and monitoring conditions such as glaucoma and macular disease, often before noticeable symptoms develop.
Used thoughtfully and when clinically appropriate, OCT helps guide informed decisions and long-term eye health planning.

Corneal Topography
Corneal topography maps the shape and curvature of the cornea, the clear front surface of the eye.
This information is particularly valuable when assessing corneal health or refining contact lens fitting, allowing for greater precision and comfort.
The result is vision correction that feels more natural and works better for your eyes.
Corneal Topography

Corneal topography maps the shape and curvature of the cornea, the clear front surface of the eye.
This information is particularly valuable when assessing corneal health or refining contact lens fitting, allowing for greater precision and comfort.
The result is vision correction that feels more natural and works better for your eyes.
Optical Biometry & Auto Refraction
These tools provide precise measurements of eye structure and refractive error, supporting accuracy during vision assessment.
They help refine prescriptions and ensure consistency, especially when combined with careful clinical evaluation and discussion.
For patients, this contributes to reliable prescriptions and comfortable vision.

Optical Biometry & Auto Refraction

These tools provide precise measurements of eye structure and refractive error, supporting accuracy during vision assessment.
They help refine prescriptions and ensure consistency, especially when combined with careful clinical evaluation and discussion.
For patients, this contributes to reliable prescriptions and comfortable vision.
Meibography & Dry Eye Imaging

Dry eye symptoms often have underlying causes that aren’t visible on the surface.
Meibography allows us to assess the health of the oil-producing glands in the eyelids, helping us understand why symptoms may be occurring and how best to manage them.
This leads to more targeted advice and a personalised approach to improving eye comfort.

Meibography & Dry Eye Imaging
Dry eye symptoms often have underlying causes that aren’t visible on the surface.
Meibography allows us to assess the health of the oil-producing glands in the eyelids, helping us understand why symptoms may be occurring and how best to manage them.
This leads to more targeted advice and a personalised approach to improving eye comfort.
Technology Used With Time and Care
Technology is most effective when there’s time to use it properly.
Our longer appointments allow us to:
Capture detailed diagnostic images
Interpret results carefully
Explain findings clearly and answer questions
Advanced imaging is used when clinically appropriate, not automatically, and always in a way that supports understanding, not confusion.
Supporting Comprehensive Eye Care
Our diagnostic technology is integrated into our broader approach to eye care, supporting services such as:
Comprehensive eye examinations
Diabetic eye assessments
Children’s vision testing
Ongoing eye health monitoring
Technology supports our care, it doesn’t replace it.
Clear Insight. Confident Care.
If you’d like to learn more about how we assess and protect your eye health using advanced diagnostic technology, we’re here to help.
Book your eye examination today and experience thoughtful, diagnostic-led eye care.

Independent, diagnostic-led optometry in Mackay.
Personalised eye care, delivered with time and care.
Reception Hours
Monday
Tuesday
Wednesday
Thursday
Friday
Saturday
Sunday
For added convenience, early appointments from 7:30 am are available on Wednesdays and Fridays.
8:30 am – 5:00 pm
8:30 am – 5:00 pm
8:30 am – 5:00 pm
8:30 am – 5:00 pm
8:30 am – 4:30 pm
8:30 am – 12:00 pm
Closed

Independent, diagnostic-led optometry in Mackay.
Personalised eye care, delivered with time and care.
Reception Hours
For added convenience, early appointments from 7:30 am are available on Wednesdays and Fridays.